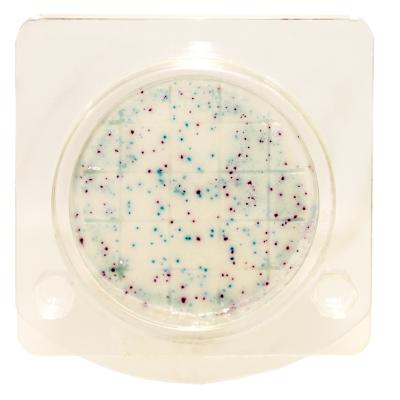

Уже 12816 пользователей с нами, зарегистрируйтесь на портале российских производителей
Саратовская область, Саратов
БФН-10000 Мобильный блок фильтрации отработанных технических ма...
СП ЭНЭКСИС
Кол-во: От 1
шт.
Цена: 670 140 ₽
Саратовская область, Саратов
БФН-5000 Мобильный блок фильтрации отработанных технических мас...
СП ЭНЭКСИС
Кол-во: От 1
шт.
Цена: 609 120 ₽
Саратовская область, Саратов
БФН-3000 Мобильный блок фильтрации отработанных технических мас...
СП ЭНЭКСИС
Кол-во: От 1
шт.
Цена: 572 580 ₽
Саратовская область, Саратов
БФН-2000 Мобильный блок фильтрации отработанных технических мас...
СП ЭНЭКСИС
Кол-во: От 1
шт.
Цена: 548 280 ₽
Саратовская область, Саратов
БФН-1000 Мобильный блок фильтрации отработанных технических мас...
СП ЭНЭКСИС
Кол-во: От 1
шт.
Цена: 523 980 ₽
Саратовская область, Саратов
БАФ-5000 Мобильный блок адсорбера с фильтрацией отработанных ма...
СП ЭНЭКСИС
Кол-во: не указано
Цена: 1 072 080 ₽
Саратовская область, Саратов
Экспресс-тест на БГКП в жидкостях (петритест)
Петритест
Кол-во: От 12
шт.
Цена: 1 800 ₽
Саратовская область, Саратов
Экспресс тест на E.coli и колиформные бактерии
Петритест
Кол-во: От 10
шт.
Цена: 1 500 ₽
Саратовская область, Саратов
Экспресс-тест на определение БГКП колиформные бактерии в т.ч.Es...
Петритест
Кол-во: От 10
шт.
Цена: 1 500 ₽
Саратовская область, Саратов
Экспресс-тест ОМЧ/КМАФАнМ (петритест)
Петритест
Кол-во: От 10
шт.
Цена: 1 500 ₽
B2B каталог для производителей и закупщиков
© «Производитель.рф», 2026
Пользуясь данным сайтом, вы соглашаетесь с пользовательским соглашением и политикой конфиденциальности
Размещенные цены не являются публичной офертой